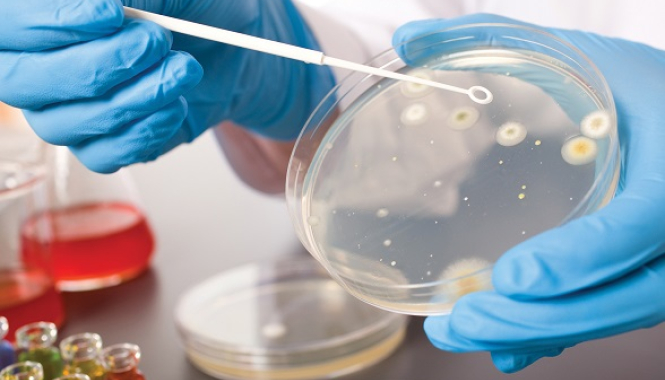
Диагностика и лечение ИППП

ИППП (инфекции/заболевания передающиеся половым путем) — это группа бактериальных, вирусных и протозойных инфекций, для которых характерен преимущественно половой путь заражения. Наиболее серьезным последствием таких заболеваний является бесплодие.
Диагностика ИППП включает в себя:
- бактериальный мазок (посев на микрофлору)
- поиск антител к возбудителю в крови
- обследование методом ПЦР (
полимеразно-цепная реакция) — это самый современный и доступный метод диагностики. ПЦР проводится по урогенитальному соскобу.
Забор материала на ПЦР не доставляет неприятных ощущений и занимает пару минут. С помощью данного метода возможно выявление основных возбудителей половых инфекций, таких, как хламидии, микоплазмы, уреаплазмы, трихомонады и др.
Полный список анализов на ИППП методами ПЦР и ИФА.
Для диагностики неспецифических кольпитов (воспаления влагалища) используется метод бактериального посева отделяемого из цервикального канала (канала шейки матки, БП5 Посев на микрофлору с определением чувствительности к антибиотикам), так как неспецифические возбудители (стафилококки, стрептококки, кишечная палочка) также могут являться причиной воспаления во влагалище и усугублять течение ИППП.
Все исследования проводятся крайне внимательно и профессионально, а главное — за очень короткий промежуток времени, что объясняет наличие собственной медицинской лаборатории.
В медицинских центрах МедЛаб представлен широкий спектр возможных вариантов лечения ИППП и воспалительных заболеваний органов малого таза:
- классическая антибиотикотерапия (по результатам ПЦР и посевов)
- физиотерапия, которая включает ультразвуковые обработки влагалища с применением антибактериальных, антисептических, противовоспалительных растворов. Хочется отметить, что данный метод оптимален в сочетании с антибактериальной терапией, что делает процесс лечения менее затратным и более эффективным и щадящим (через
желудочно-кишечный тракт и систему печени проходит меньшее количество лекарственных веществ); - лазеротерапия — с помощью тонких проводников в своды влагалища также направлена на уменьшение воспалительных проявлений(снятие отёка тканей, покраснения, зуда во влагалище, стимуляция местного иммунитета), улучшение кровообращения в органах малого таза.
- Антибактериальная терапия и физиотерапия может сочетаться с применением модуляторов общего иммунитета и др.
Записаться
- женщинам Гинеколог, гинеколог-эндокринолог
- мужчинам Уролог, андролог.
Рубрика
Статьи о заболеванияхРекомендуемые обследования:
УЗИ матки и придатков 2 400 — 2 700 ₽
Микроскопическое исследование соскобов из женских половых органов (микробиоценоз, 3 точки) 870 ₽
Микроскопическое исследование соскоба из уретры, мужчины (микробиоценоз) 510 ₽
Фемофлор 16 (оценка биоценоза урогенитального тракта у женщин) 4 300 ₽
Андрофлор (оценка биоценоза урогенитального тракта у мужчин) 4 300 ₽
Посев на микрофлору с чувствительностью к антибиотикам (БП5: отделяемое половых органов) 1 900 ₽
Инфекции – ЗППП 4 теста (реал-тайм ПЦР, кол.) 1 280 ₽
ДНК-типирование ВПЧ (27 типов, ПЦР) 1 260 ₽
ФЛОРОскрин 16 (оценка биоценоза урогенитального тракта у женщин) 3 600 ₽
Максимальная диагностика ИППП (ЗППП) и ВПЧ (13+27 тестов, кол.) 4 710 ₽